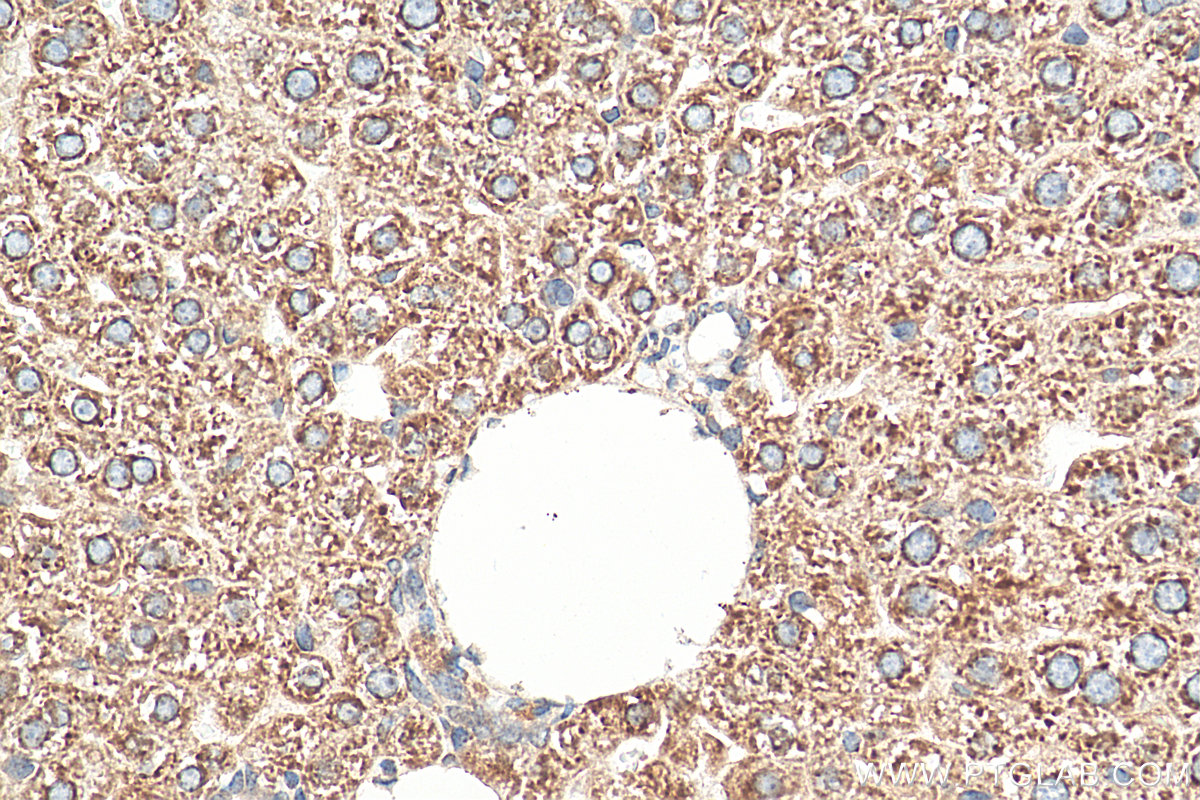

验证数据展示
产品信息
14846-1-PBS targets SEC61B-Specific in WB, IHC, IF/ICC, IF-P, Indirect ELISA applications and shows reactivity with human, mouse, rat samples.
| 经测试应用 | WB, IHC, IF/ICC, IF-P, Indirect ELISA Application Description |
| 经测试反应性 | human, mouse, rat |
| 免疫原 |
Peptide 种属同源性预测 |
| 宿主/亚型 | Rabbit / IgG |
| 抗体类别 | Polyclonal |
| 产品类型 | Antibody |
| 全称 | Sec61 beta subunit |
| 别名 | |
| 计算分子量 | 10 kDa |
| 观测分子量 | 10-15 kDa |
| GenBank蛋白编号 | NM_006808 |
| 基因名称 | SEC61B |
| Gene ID (NCBI) | 10952 |
| RRID | AB_2270168 |
| 偶联类型 | Unconjugated |
| 形式 | Liquid |
| 纯化方式 | Antigen affinity purification |
| UNIPROT ID | P60468 |
| 储存缓冲液 | PBS only, pH 7.3. |
| 储存条件 | Store at -80°C. The product is shipped with ice packs. Upon receipt, store it immediately at -80°C |
背景介绍
The heteromeric SEC61 complex is composed of alpha, beta and gamma subunits. Oligomers of the SEC61 complex form a transmembrane channel where proteins are translocated across and integrated into the ER membrane (PMID: 10212142). SEC61B is the beta subunit of the SEC61 complex. It has been reported that SEC61B facilitates cotranslational protein transport and interacts with the signal peptidase during translocation (PMID: 9585408).